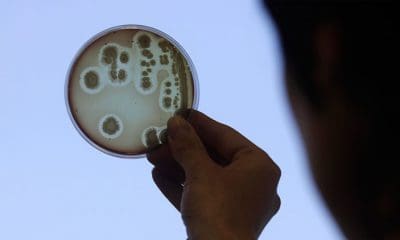
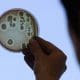

Un equipo internacional de científicos ha encontrado una nueva vía para impedir que el virus de la inmunodeficiencia humana (VIH), causante del síndrome de inmunodeficiencia adquirida...



Todavía no hemos llegado a superar a las series y películas de ficción, pero Hitachi ha introducido hoy un sistema que, al menos, promete predecir dónde...



Científicos del Instituto de Métrica y Evaluación de la Salud de la Universidad de Washington (EE.UU.) revelaron las principales causas de mortalidad en el mundo y...



El reciente descubrimiento de la nueva especie humana Homo naledi cerca de Johannesburgo, Sudáfrica, no ha sido bien recibido por toda la sociedad. Algunos políticos y...

La creciente capacidad de algunos de los antibióticos de resistir a las ‘superenfermedades’ y a las ‘superbacterias’ podría causar el ‘apocalipsis’, según estiman varios expertos. Presentamos...



Aunque el experimento busca ser una promesa para aquellos hombres que desean ser padres y no pueden, aún faltarían pruebas para comprobar la efectividad del mismo,...



El calentamiento global, combinado con fenómenos naturales como El Niño, tendrá como consecuencia temperaturas muy elevadas en lo que queda del año y en 2016, según...



Uno de los acontecimientos más importantes para la ciencia nuclear a nivel mundial ha tenido lugar este viernes, 11 de septiembre, en la ciudad rusa de...



Restos de una nueva especie relacionada con la evolución humana fueron localizados al noreste de Sudáfrica.



¿Y si todo lo que supiéramos acerca del VIH fuera sólo una gota de agua en medio del océano? Una nueva investigación publicada en Cell Reports muestra un mecanismo tan...